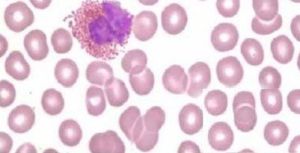
播散性嗜酸粒細胞增多性膠原病

流行病學
發病年齡自6個月到47歲不等,平均為19歲,男女發病之比為13∶10。病因
確切病因目前尚不清楚。因有嗜酸粒細胞增多、哮喘和血清IgE升高,故可能是由某種原因所致的Ⅰ型超敏反應介導的疾病。發病機制
發病機制還不確切。可能是Ⅰ型超敏反應介導的疾病從關節肌肉疼痛、結節性多動脈炎樣血管炎來看,本病又近似於風濕病,故Ⅲ型超敏反應有重要致病作用。至於Ⅰ型Ⅲ型超敏反應如何協同致病,尚有待於研究。病理:顯微鏡下可見表皮角化過度、部分角化不全、表皮突不規則延長等,並非所有病例均有表皮改變,但均有真皮改變,表現為真皮膠原纖維疏鬆水腫,淺層有局限性類纖維蛋白改變。從真皮淺層到中層在毛細血管、小血管及汗腺等周圍有中度嗜酸粒細胞和組織細胞、少量淋巴細胞及漿細胞浸潤。全身各臟器主要表現為血管炎及間質炎,部分臟器表現有以壞死並伴嗜酸粒細胞浸潤為主的肉芽腫。本病的組織病理改變有以下特徵:①纖維結締組織發生類纖維蛋白變性及類纖維蛋白壞死;②血管炎,主要為小血管病變;③比較成熟的嗜酸粒細胞瀰漫性浸潤及肉芽腫形成。
臨床表現
主要表現為乏力、全身酸痛不適、食慾不佳、煩躁和失眠等。本病與其他膠原病一樣,也具有多系統損害的特徵。
1.發熱 幾乎所有病例均有發熱,並且多與病變的活動性平行可為弛張熱,也可為稽留熱,體溫多在38℃以上。
2.關節症狀 表現為多關節炎或關節痛,有時出現關節腔積液、關節腫脹。關節症狀時輕時重,重時活動受限,晨起僵直但多不引起關節變形。全身關節均可受累,但以四肢關節較多見,尤其手部關節最易受累。有些病例尚伴有肌肉疼痛和肌無力。
3.皮損 皮膚改變有如下幾種類型:①紅斑、多形性紅斑;②丘疹;③皮炎、斑塊、黃色瘤樣損害;④壞死、瘢痕;⑤紅皮症。可一種皮疹單獨存在也可幾種同時並存或相繼出現,其中以額面及軀幹部粟粒樣丘疹為早期最常見的皮膚改變,隨著病情發展,可逐漸向四肢擴散,並轉變為蕁麻疹樣紅斑、風團或異位性皮炎樣皮疹,伴有劇烈瘙癢感。開始出現的粟粒丘疹也可很快轉變為全身皮膚發紅、增厚與脫屑,多伴有劇癢即所謂紅皮症樣皮疹。有時可伴有四肢苔蘚樣變,皮損消退後留有細網狀色素沉著。皮損也可一開始就表現為散在性分布於全身的邊緣清楚的紅斑,其大小如雞蛋或手掌不等,邊緣呈鮮紅色,中心部顏色較淡,並稍高起皮膚。紅斑間雜有淡褐色色素沉著常相互融合,形成斑塊或黃色瘤樣改變。紅斑嚴重時可發生局部壞死,消退後留有瘢痕。身體不同部位可出現不同類型的皮損,如軀幹部常表現為紅斑、多形性滲出性紅斑樣損害,而四肢則表現為粟粒樣丘疹或異位性皮炎樣皮疹總之,本病皮膚改變具有多樣性,但其恆有特徵為播散性,多伴有瘙癢感。
4.心肺症狀 在病變發作活動期多數病人都有呼吸道症狀,表現為不同程度的咳嗽,有時為哮喘樣呼吸困難咳泡沫樣痰或黏液痰,痰塗片中嗜酸粒細胞增多。由於肺組織有嗜酸粒細胞浸潤,可引起一過性肺炎症狀。由於長期套用糖皮質激素治療可使機體抵抗力下降,極易繼發細菌感染最後導致支氣管肺炎,使病情加重並成為本病的死亡原因。
半數以上病人有心臟擴大,但早期多無症狀,後期可發生充血性心力衰竭。幾乎所有病例均有竇性心動過速。心率與體溫分離。
5.消化道症狀 可表現腹痛、噁心、嘔吐偶爾有腹瀉或便秘,或兩者交替出現,這可能是由於胃腸道嗜酸粒細胞浸潤所造成的。約半數以上病人有肝、脾大。
6.神經症狀 部分病例可出現神經系統症狀,表現為步態障礙、意識障礙視力障礙、四肢軟癱、眼瞼下垂、顱內高壓征及病理反射等。
7.其他 約1/3的病人有淋巴結腫大可為全身淋巴結腫大,也可為局部淋巴結腫大,尤以頸和腋窩淋巴結腫大為最常見。
併發症:
本病可並發關節腔積液;關節變形;肌無力;紅斑、多形性紅斑;丘疹;皮炎、斑塊、黃色瘤樣損害;壞死、瘢痕;紅皮症。一過性肺炎支氣管肺炎,心臟擴大肝、脾大。
診斷
本病診斷主要依靠皮損、臨床表現、病理特徵及外周血象嗜酸粒細胞增多,結合多系統受累特徵,即可獲得診斷。
鑑別診斷:
必須排除以下伴有嗜酸粒細胞增多的疾病:
1.結節性多動脈炎 以內臟損害為主,尤以心、腎、神經系統症狀為顯著。皮損以紫斑或沿動脈走向分布的結節為主,多無瀰漫性瘙癢性粟粒丘疹或斑塊病理改變以纖維壞死性中、小動脈炎為主,多無表皮、真皮膠原纖維改變。類風濕因子和抗核抗體陰性。這些病理及實驗室異常均不同於播散性嗜酸粒細胞增多性膠原病。
2.變應性肉芽腫 系一種多系統器官受累的肉芽腫性血管炎以肺部浸潤為主表現為發作性哮喘、周圍血象嗜酸粒細胞增多。皮損主要為皮膚或皮下結節、紫斑。病理改變為類纖維蛋白壞死性血管炎,主要累及肌層動脈,伴有肉芽腫樣改變。無皮膚膠原纖維改變,類風濕因子抗核抗體均為陰性。
3.韋格內肉芽腫 為一種壞死性肉芽腫性血管炎。主要累及呼吸道腎臟和眼部,常有上呼吸道骨質破壞無瘙癢性粟粒性丘疹、斑塊,無皮膚膠原纖維改變抗核抗體陰性IgE水平正常。
檢查
實驗室檢查:
1.血常規及血沉 白細胞總數可增加,而分類計數隻恆有嗜酸粒細胞升高,大多為成熟型。活動期多有血沉增快。
2.尿常規 可有輕度蛋白尿、鏡下血尿或管型尿,尿液改變一般較輕。
3.生化學檢查 可有肝功能輕度異常,蛋白電泳可顯示γ球蛋白升高。
4.免疫學檢查 所有病例均有IgEIgG升高,2/3的病人類風濕因子陽性,約1/5的病人抗核抗體陽性,E-玫瑰花結形成數及PHA等標誌細胞免疫試驗多低下補體多降低。
其它輔助檢查:
X線檢查 胸片多有不同程度的炎性浸潤,有時可見心臟增大。個別病例可有手部畸形關節腔變窄、骨質破壞,偶爾可見關節脫位或半脫位。
治療
本病的基本治療方法是用免疫抑制劑或糖皮質激素控制反覆發作。因病變遷延不愈需長期套用激素時,宜採用小劑量隔天療法在用藥過程中一旦肺部症狀加重,並伴持續性高熱,即提示肺部繼發感染,此時需用足量有效的抗生素控制感染。
預後預防
預後:
較好,但常反覆發作,可死於肺部繼發感染。
預防:
1.消除和減少或避免發病因素,改善生活環境空間,養成良好的生活習慣,防止感染,注意飲食衛生,合理膳食調配。
2.注意鍛鍊身體,增加機體抗病能力不要過度疲勞、過度消耗,戒菸戒酒保持平衡心理,克服焦慮緊張情緒。
3.早發現早診斷早治療原發病,樹立戰勝疾病的信心堅持治療。
4.預防感染,預防鏈球菌感染是自身免疫性風濕性疾病及並發病的重要環節。